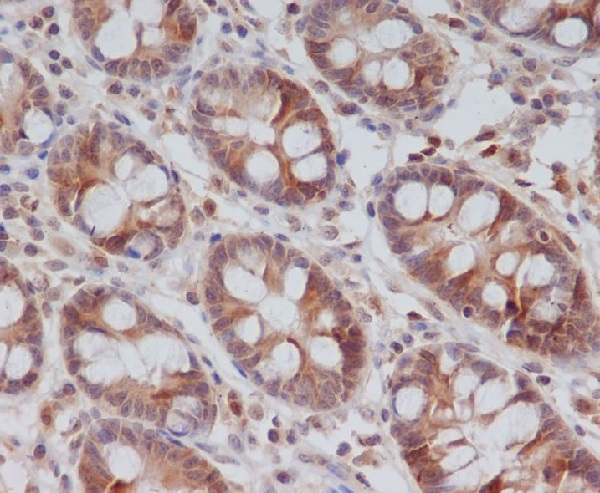
Cyclin B2 Antibody in Immunohistochemistry (Paraffin) (IHC (P))

Search
Invitrogen
Cyclin B2 Recombinant Rabbit Monoclonal Antibody (K01_3S82)
{{$productOrderCtrl.translations['antibody.pdp.commerceCard.promotion.promotions']}}
{{$productOrderCtrl.translations['antibody.pdp.commerceCard.promotion.viewpromo']}}
{{$productOrderCtrl.translations['antibody.pdp.commerceCard.promotion.promocode']}}: {{promo.promoCode}} {{promo.promoTitle}} {{promo.promoDescription}}. {{$productOrderCtrl.translations['antibody.pdp.commerceCard.promotion.learnmore']}}
产品信息
MA566944
种属反应
宿主/亚型
Expression System
分类
类型
克隆号
抗原
偶联物
形式
浓度
规格
纯化类型
保存液
内含物
保存条件
运输条件
靶标信息
Cyclin B2 is a member of the cyclin family, specifically the B-type cyclins. The B-type cyclins, B1 and B2, associate with p34cdc2 and are essential components of the cell cycle regulatory machinery. B1 and B2 differ in their subcellular localization. Cyclin B1 co-localizes with microtubules, whereas cyclin B2 is primarily associated with the Golgi region. Cyclin B2 also binds to transforming growth factor beta RII and thus cyclin B2/cdc2 may play a key role in transforming growth factor beta-mediated cell cycle control.
仅用于科研。不用于诊断过程。未经明确授权不得转售。
篇参考文献 (0)
生物信息学
蛋白别名: CCNB2; CYC-B2; G2/mitotic-specific cyclin B2; G2/mitotic-specific cyclin-B2; unnamed protein product
基因别名: CCNB2; CycB2; HsT17299
UniProt ID: (Human) O95067, (Mouse) P30276
Entrez Gene ID: (Human) 9133, (Rat) 363088, (Mouse) 12442